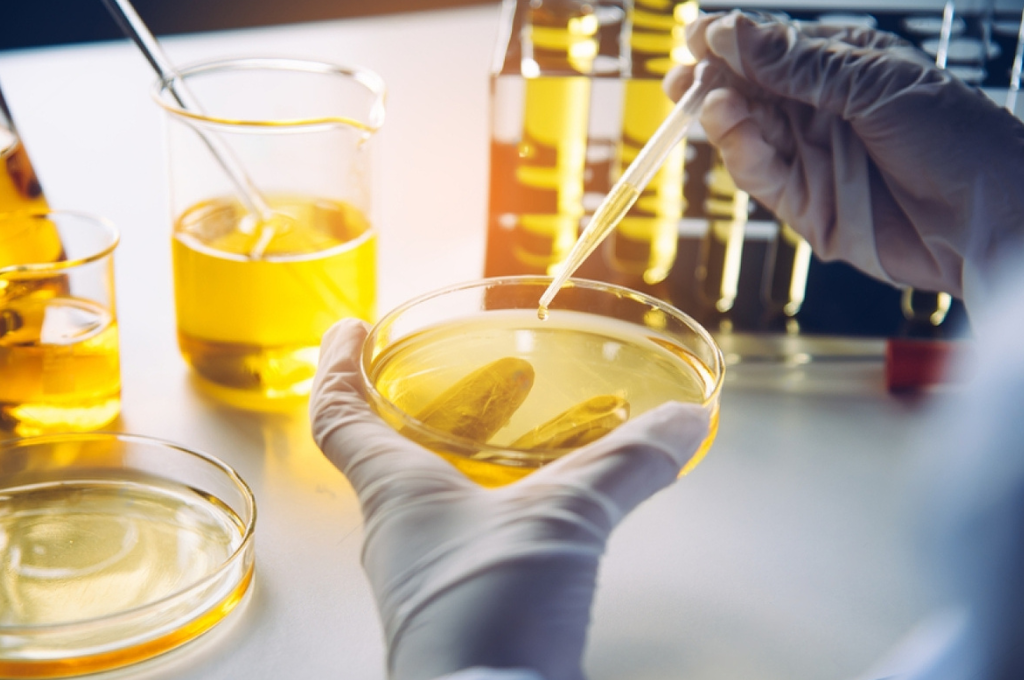
Pure Nicotine Liquid India

In India, the availability of pure nicotine liquid is subject to regulations and safety standards. When seeking pure nicotine liquid, it's crucial to ensure compliance with applicable laws and prioritize quality and safety.
1. Regulatory Landscape:
Central Drugs Standard Control Organization (CDSCO):
- Pure nicotine liquid falls under the purview of the CDSCO, the regulatory authority for pharmaceuticals and medical devices in India.
- Ensure that suppliers comply with CDSCO regulations to guarantee product safety.
Bureau of Indian Standards (BIS):
- Check if the pure nicotine liquid adheres to standards set by the BIS, which establishes benchmarks for product quality and safety.
- BIS certification is an indicator of compliance with Indian standards.
2. Supplier Verification:
Reputable Vendors:
- Choose reputable suppliers with a history of providing high-quality products.
- Check for certifications, such as ISO (International Organization for Standardization), to verify the supplier's commitment to quality.
Customer Reviews:
- Look for customer reviews and testimonials to gauge the experiences of other buyers.
- Positive feedback can be indicative of a reliable and trustworthy supplier.
3. Certificates of Analysis (CoA):
Transparency in Composition:
- Prioritize suppliers that provide Certificates of Analysis (CoA) for their pure nicotine liquid.
- CoA offers detailed information on the composition and purity of the product.
Verification of Quality:
- Regular testing and documentation through CoA contribute to the verification of the product's quality.
- CoA serves as a crucial document for quality assurance.
4. Packaging and Safety Measures:
Secure Packaging:
- Ensure that the pure nicotine liquid is securely packaged to prevent exposure and spillage.
- Child-resistant packaging is often mandated to enhance safety.
Safety Labeling:
- Clear and comprehensive labeling, including warnings and safety instructions, is crucial for safe handling and use.
- Proper education on safe practices contributes to user awareness.
5. Compliance with International Standards:
USP (United States Pharmacopeia) Standards:
- While not mandatory, products adhering to international standards, such as USP, demonstrate a commitment to quality.
- USP-grade products often signify higher purity levels.
6. Local Regulations and Importation:
Customs and Import Regulations:
- Understand customs and import regulations related to pure nicotine liquid in India.
- Ensure that the importation process complies with Indian laws and regulations.
Local Restrictions:
- Be aware of any local restrictions or regulations specific to the state or region within India.
- Compliance with local laws is essential for the legal procurement of pure nicotine liquid.
As a Article you can also learn about:
- Supernic - A Step-by-Step Guide
- Nicotine Tincture
- Premium Nic Salts in India
- Nicotine Bitartrate Dihydrate Manufacturer
- Nicotine Polacrilex Formula
- 100% Nicotine Vape Juice
- Nicotine Extract Solution (99.5%)
- Nicotine Benzoate Supplier in 1kg
- Utra-High Purity Nicotine
Responsible Sourcing for Safety and Quality
When seeking pure nicotine liquid in India, responsible sourcing is paramount. Adherence to regulatory standards, transparency through Certificates of Analysis, and choosing reputable suppliers contribute to ensuring the safety and quality of the product. By navigating the regulatory landscape and prioritizing quality assurance measures, users and manufacturers can confidently engage in the procurement of pure nicotine liquid in India.